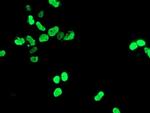
HOXC11 Antibody in Immunocytochemistry (ICC/IF)

Search
OriGene
HOXC11 Monoclonal Antibody (OTI1F8), TrueMAB™
{{$productOrderCtrl.translations['antibody.pdp.commerceCard.promotion.promotions']}}
{{$productOrderCtrl.translations['antibody.pdp.commerceCard.promotion.viewpromo']}}
{{$productOrderCtrl.translations['antibody.pdp.commerceCard.promotion.promocode']}}: {{promo.promoCode}} {{promo.promoTitle}} {{promo.promoDescription}}. {{$productOrderCtrl.translations['antibody.pdp.commerceCard.promotion.learnmore']}}
产品信息
TA502571
种属反应
宿主/亚型
分类
类型
克隆号
抗原
偶联物
形式
浓度
纯化类型
保存液
内含物
保存条件
运输条件
靶标信息
This gene belongs to the homeobox family of genes. The homeobox genes encode a highly conserved family of transcription factors that play an important role in morphogenesis in all multicellular organisms. Mammals possess four similar homeobox gene clusters, HOXA, HOXB, HOXC and HOXD, which are located on different chromosomes and consist of 9 to 11 genes arranged in tandem. This gene is one of several homeobox HOXC genes located in a cluster on chromosome 12. The product of this gene binds to a promoter element of the lactase-phlorizin hydrolase. It also may play a role in early intestinal development. An alternatively spliced variant encoding a shorter isoform has been described but its full-length nature has not been determined.
仅用于科研。不用于诊断过程。未经明确授权不得转售。
篇参考文献 (0)
生物信息学
蛋白别名: homeo box C11; Homeobox protein Hox-3H; Homeobox protein Hox-C11; MGC4906
基因别名: HOX3H; HOXC11
UniProt ID: (Human) O43248
Entrez Gene ID: (Human) 3227